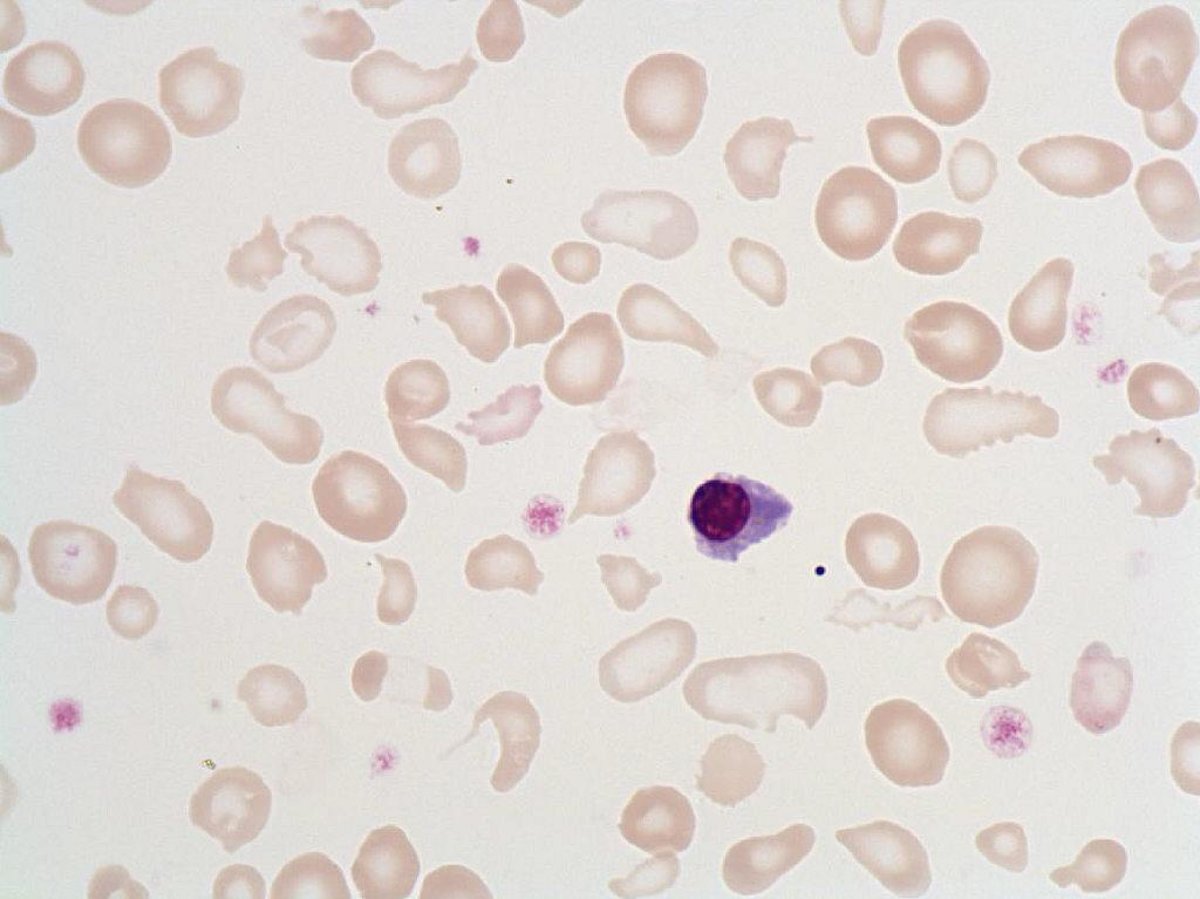
Poikilocytosis

Poikilocytosis
- Size : N/A
- Normal values : Absent in the blood
- Description / Pathology :
Red blood cells of variable shapes.
Various dyserythropoiesis, hemoglobinopathies.
Red blood cells of variable shapes.
Various dyserythropoiesis, hemoglobinopathies.